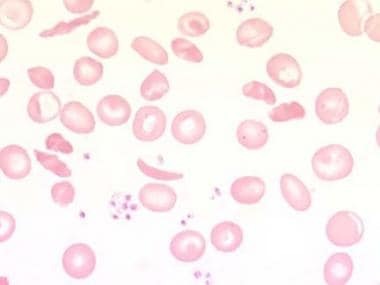

Anaemia: Types and Management
M3 India Newsdesk Mar 12, 2025
The article provides an in-depth overview of anaemia. It is a condition characterised by a decrease in the number of red blood cells (RBCs) or haemoglobin concentration, leading to reduced oxygen-carrying capacity of the blood. It can result in fatigue, weakness, shortness of breath, & other symptoms.
Anaemia is a condition characterised by a decrease in the number of red blood cells (RBCs) or haemoglobin concentration, leading to reduced oxygen-carrying capacity of the blood. It can result in fatigue, weakness, shortness of breath, and other symptoms.
Causes of anaemia

There are various causes of anaemia, which can be broadly categorised into three main mechanisms:
1. Decreased production of red blood cells
This occurs when the bone marrow does not produce enough RBCs due to various reasons, including:
Nutritional deficiencies
- Iron deficiency (most common worldwide): The most common cause of anaemia, often due to inadequate dietary intake, poor absorption (e.g., celiac disease), or chronic blood loss (e.g., heavy menstrual periods, gastrointestinal bleeding).
- Vitamin B12 and folate deficiencies: Vitamin B12 Deficiency is often caused by poor dietary intake (e.g., in vegans) or malabsorption (e.g., pernicious anaemia, gastrointestinal surgery, or Crohn's disease).
- Folate deficiency: Due to inadequate dietary intake, increased requirements (e.g., pregnancy), or malabsorption (e.g., alcoholism).
- Bone marrow disorders: Aplastic anaemia (failure of bone marrow to produce RBCs), Myelodysplastic syndromes, Leukaemia or other cancers affecting the bone marrow.
2. Chronic diseases
- Chronic kidney disease
- Cancer
- autoimmune disorders can suppress RBC production
3. Blood loss
- Acute: Trauma or surgery
- Chronic: Menorrhagia, gastrointestinal bleeding
4. Inherited disorders
- Sickle cell disease
- Thalassemia
5. Bone Marrow Disorders
- Aplastic anaemia
- Leukaemia
6. Other causes
- Parasitic infections (e.g., malaria, hookworm)
- Infections (e.g., tuberculosis, HIV)
Types of anaemia
Iron deficiency anaemia
- Caused by insufficient dietary iron or chronic blood loss.
- Iron deficiency anaemia occurs when the body lacks enough iron to produce adequate levels of haemoglobin, the protein in red blood cells that carries oxygen.
- It is one of the most common types of anaemia and can result from various causes.
Megaloblastic anaemia
- Due to vitamin B12 or folate deficiency.
- Megaloblastic anaemia is a type of anaemia characterised by the presence of abnormally large, immature red blood cells (megaloblasts) in the bone marrow.
- This condition occurs due to impaired DNA synthesis, often caused by deficiencies of vitamin B12, folate, or both.
Haemolytic anaemia
- Caused by premature destruction of RBCs.
- Haemolytic anaemia is a condition where red blood cells (RBCs) are destroyed (haemolysis) faster than they can be produced.
- This leads to a shortage of RBCs, which impairs the blood's ability to carry oxygen.
Aplastic anaemia
- Aplastic anaemia is a rare and serious condition in which the bone marrow fails to produce enough blood cells (red blood cells, white blood cells, and platelets).
- This deficiency leads to pancytopenia, a shortage of all types of blood cells.
Anaemia of chronic disease
- Anaemia of chronic disease (ACD), also called anaemia of inflammation, is a type of anaemia that occurs in people with chronic infections, inflammatory diseases, or certain malignancies.
- It is characterised by low red blood cell production due to dysregulated iron metabolism and impaired erythropoiesis.
- It is associated with long-term medical conditions.
Symptoms and signs
A. Iron deficiency anaemia
It may vary depending on the severity of the condition. They are primarily due to reduced oxygen delivery to tissues and other physiological effects of low iron levels.
Common symptoms
- General

- Fatigue and weakness
- Pale skin and mucous membranes
- Shortness of breath, especially during physical activity
- Dizziness or lightheadedness
- Cardiovascular symptoms
- Rapid or irregular heartbeat (palpitations)
- Chest pain (in severe cases)
- Neurological symptoms
- Difficulty concentrating or "brain fog"
- Restless legs syndrome (a crawling or uncomfortable sensation in the legs, relieved by movement)
- Cold intolerance
Feeling cold more often than usual.
- Unusual cravings (pica)
Cravings for non-nutritive substances like ice, dirt, or chalk.
- Hair, skin, and nails
- Brittle or spoon-shaped nails (koilonychia)
- Dry, damaged hair or hair loss
- Cracked corners of the mouth (angular cheilitis)
- Gastrointestinal symptoms
- Sore or inflamed tongue (glossitis)
- Difficulty swallowing (rare)
Severe (if untreated) symptoms
- Extreme fatigue and inability to perform daily tasks.
- Development of heart failure due to prolonged oxygen deprivation.
- If you suspect iron deficiency anaemia, consult a healthcare provider for a proper diagnosis and treatment plan.
B. Megaloblastic anaemia
These are seen due to a deficiency in red blood cells due to impaired DNA synthesis, often resulting from vitamin B12 or folate deficiency. Symptoms may develop gradually and include both general anaemia symptoms and specific neurological or gastrointestinal signs.
Common symptoms
- General
- Fatigue and weakness
- Pale or yellowish skin (jaundice)
- Shortness of breath, especially during physical activity
- Dizziness or lightheadedness
- Rapid or irregular heartbeat (palpitations)
- Neurological (specific to B12 deficiency)
- Numbness or tingling in the hands and feet (paraesthesia)
- Difficulty walking or balance problems
- Muscle weakness
- Cognitive issues such as memory loss, confusion, or difficulty concentrating.
- Mood changes, including irritability or depression
- Gastrointestinal
- Sore or inflamed tongue (glossitis)
- Loss of appetite or weight loss
- Diarrhoea or constipation
- Other findings
- Smooth, red tongue
- Brittle nails or hair thinning
Severe (if untreated) symptoms
- Persistent neurological damage (from untreated B12 deficiency).
- Increased risk of heart failure due to prolonged anaemia. Development of complications like infertility or neural tube defects during pregnancy (folate deficiency).
- If symptoms of megaloblastic anaemia are present, consult a healthcare professional for diagnosis and treatment to prevent complications.
C. Haemolytic anaemia
It results from the rapid destruction of red blood cells (RBCs) faster than the bone marrow can replace them. The severity and specific symptoms depend on the rate of haemolysis, whether the condition is acute or chronic, and the underlying cause.
Common symptoms
- General
- Fatigue and weakness
- Pale or yellowish skin (due to anaemia and jaundice)
- Shortness of breath, especially during physical activity
- Dizziness or lightheadedness
- Related to haemolysis
- Jaundice: Yellowing of the skin and eyes due to increased bilirubin from RBC break-down
- Dark-coloured urine: Due to the presence of haemoglobin or urobilinogen
- Splenomegaly: Enlarged spleen, causing discomfort or pain in the left upper abdomen
- Gallstones: Resulting from chronic haemolysis and excess bilirubin
Severe haemolysis (acute cases)
- Rapid heart rate (tachycardia)
- Severe fatigue or collapse
- Abdominal or back pain
Specific symptoms based on cause
1. Inherited forms
- Sickle cell anaemia: Episodes of pain ( vaso-occlusive crises), delayed growth, and frequent infections.
- Thalassemia: Bone deformities, especially in the face, and delayed development.
- G6PD deficiency: Haemolytic episodes triggered by certain drugs, infections, or foods (e.g., fava beans).
2. Acquired forms
- Autoimmune haemolytic anaemia: Symptoms may worsen rapidly and include fever or chills.
- Microangiopathic haemolytic anaemia (e.g., TTP, HUS): Associated with kidney failure, neurological symptoms, or bleeding.
Severeity and Complications
- Heart failure from chronic anaemia.
- Iron overload (in cases requiring repeated blood transfusions).
- Increased risk of life-threatening infections after splenectomy.
- If you experience symptoms of haemolytic anaemia, consult a healthcare provider promptly for diagnosis and management.
- Early treatment can prevent complications.
D. Aplastic anaemia
Aplastic anaemia is a rare but serious condition where the bone marrow fails to produce enough blood cells. Symptoms often result from the deficiency of red blood cells, white blood cells, and platelets.
Common symptoms
- Due to Low Red Blood Cells (Anaemia)
- Fatigue and weakness
- Pale skin
- Shortness of breath
- Dizziness or lightheadedness
- Cold hands and feet
- Due to low white blood cells (Neutropenia)
- Frequent or severe infections
- Fever
- Prolonged recovery from illnesses
- Due to low platelets (Thrombocytopenia)
- Easy bruising or bleeding
- Nosebleeds or bleeding gums
- Prolonged bleeding from cuts
- Petechiae (small red spots under the skin caused by bleeding)
- Other possibilities
- Headaches
- Rapid or irregular heart rate (due to anaemia)
- Unexplained weight loss
If you suspect aplastic anaemia, it is crucial to seek medical attention promptly, as it may lead to life-threatening complications. Diagnosis typically requires blood tests and a bone marrow biopsy.
E. Anaemia of chronic disease
Anaemia of chronic disease (ACD), also called anaemia of inflammation, is commonly associated with chronic conditions like infections, inflammatory diseases, or cancer. Its symptoms are often mild and develop gradually, making them less noticeable than in other types of anaemia.
Common symptoms
- Fatigue and weakness: Feeling tired or lacking energy
- Pale skin: Skin may appear paler than usual.
- Shortness of breath: Particularly noticeable during physical activity.
- Mild dizziness or lightheadedness: Feeling faint or dizzy at times.
- Reduced exercise tolerance: Difficulty performing physical tasks that were previously manageable.
- Headaches: This may occur due to reduced oxygen delivery to the brain.
- Cold hands and feet: The sensation of chilliness due to poor oxygenation.
- Symptoms of the Underlying chronic condition: Symptoms related to the primary illness (e.g., joint pain in rheumatoid arthritis, fever in infections).
ACD often coexists with other forms of anaemia, such as iron deficiency anaemia, and its severity depends on the underlying condition. If you suspect anaemia of chronic disease, consult a healthcare professional for proper evaluation and management.
Prevalence of anaemia globally
Key statistics
1. Global burden:
- Anaemia affects approximately 1.8 billion people worldwide, which is about 23% of the global population
- Women and children are disproportionately affected
2. By population:
- Pregnant Women: ~40% globally
- Non-pregnant Women (15–49 years): ~30%
- Children under 5 years: ~43%
3. By region:
Africa
- The highest prevalence is due to nutritional deficiencies and infectious diseases.
- Over 60% of children under five are anaemic in some sub-Saharan countries.
South Asia
- High prevalence due to iron-deficient diets and poor healthcare access.
- India has one of the highest global burdens.
Southeast Asia
Anaemia affects ~50% of women and children.
Latin America & the Caribbean
Moderate prevalence with improvements due to better nutrition programs.
Europe & North America
Relatively low prevalence, mainly seen in specific groups (e.g., older adults, vegetarians).
Urban vs Rural
Rural areas tend to have higher prevalence due to poverty, poor access to healthcare, and, higher rates of parasitic infections.
Consequences of anaemia
1. Health impacts
- Reduced work capacity and productivity.
- Impaired cognitive and physical development in children.
- Increased maternal and perinatal mortality.
2. Economic burden
Healthcare costs and loss of productivity significantly strain economies, particularly in low-income countries.
Interventions
- Nutritional strategies
- Iron and folic acid supplementation
- Fortification of staple foods
- Promoting diversified diets rich in iron, vitamins, and minerals
- Public health measures:
- Control of parasitic infections (e.g., deworming)
- Malaria prevention programs
- Improving sanitation to reduce hookworm transmission
- Healthcare services:
- Screening and treatment for anaemia during pregnancy
- Early diagnosis and management of underlying conditions
- Education and awareness:
- Public education campaigns to improve dietary practices
- Community-based initiatives to enhance healthcare access
Treatment of anaemia
Treatment of anaemia depends on its cause and severity. The main goals are to restore normal haemoglobin levels, address underlying conditions, and alleviate symptoms.
- General principles of treatment.
- Identify the cause: Comprehensive evaluation through history, physical examination, and laboratory tests.
- Correct deficiencies: Replace missing nutrients such as iron, vitamin B12, or folate.
- Treat underlying conditions: Manage chronic diseases or infections contributing to anaemia.
- Symptomatic management: In severe cases, blood transfusions may be necessary.
Specific treatments
Iron deficiency anaemia
- Oral iron therapy
- Medications: Ferrous sulphate, ferrous gluconate, or ferrous fumarate
- Dosage: Typically, 100-200 mg of elemental iron daily
- Duration: 3-6 months to replenish iron stores
- Side Effects: Constipation, nausea, dark stools
- Take with vitamin C to enhance absorption
- Intravenous (IV) Iron therapy
- Indicated in cases of severe deficiency, malabsorption, or intolerance to oral iron
- Common formulations: Ferric carboxy-maltose, iron sucrose
- Dietary Changes
- Foods rich in iron: Red meat, poultry, fish, legumes, leafy greens, fortified cereals
- Avoid tea and coffee during meals as they inhibit iron absorption
Vitamin B12 deficiency anaemia
1. Vitamin B12 supplementation
- Oral Form: For mild deficiency
- Intramuscular Injections: Cyanocobalamin or hydroxocobalamin for severe deficiency
- Frequency: Daily or weekly until normalised, then maintenance doses
2. Dietary sources
- Meat, fish, eggs, dairy products
- Fortified foods for vegetarians and vegans
Folate deficiency anaemia
1. Folic acid supplements
- 1-5 mg daily until deficiency is corrected
- Long-term supplementation may be needed in chronic conditions
2. Dietary sources
Greens, citrus fruits, nuts, beans, and fortified grains
Anaemia of chronic disease
- Treat the underlying cause: Manage the chronic disease (e.g., kidney disease, cancer, autoimmune disorders).
- Erythropoiesis-Stimulating Agents (ESAs): Used in chronic kidney disease or chemotherapy-induced anaemia. Examples: Epoetin alfa, darbepoetin alfa.
- Iron Therapy: Often combined with ESAs if iron deficiency coexists.
Haemolytic anaemia
- Treat the underlying cause: Stop offending drugs or manage infections.
- Corticosteroids: For immune-mediated haemolysis (e.g., autoimmune haemolytic anaemia).
- Splenectomy: Considered in refractory cases.
- Blood Transfusions: For severe anaemia or crisis.
- Folic Acid Supplementation: To support increased RBC production.
Aplastic anaemia
- Immunosuppressive Therapy: Anti-thymocyte globulin (ATG) and cyclosporine.
- Bone Marrow Transplantation: Curative option, especially in younger patients with a matched donor.
- Supportive Care: Blood transfusions, and antibiotics for infections.
Thalassemia and sickle cell anaemia
- Regular Blood Transfusions: To maintain haemoglobin levels.
- Iron Chelation Therapy: To prevent iron overload due to frequent transfusions (e.g., deferoxamine, deferasirox).
- Hydroxyurea: Used in sickle cell anaemia to reduce pain crises and improve quality of life.
- Bone Marrow Transplantation: Potential curative therapy.
- Blood Transfusion:
- Indicated in severe anaemia with symptoms like shortness of breath, fatigue, or hemodynamic instability
- Risks: Iron overload, allergic reactions, infections
- Lifestyle and Supportive Measures
- Balanced Diet: Ensure adequate intake of iron, B12, folate, and protein
- Manage Chronic Conditions: Regular follow-ups for conditions like diabetes, cancer, or autoimmune diseases
- Avoid risk factors
- Limit alcohol (impairs RBC production)
- Prevent parasitic infections through sanitation and deworming
- Monitoring and follow-up
Regular haemoglobin and ferritin testing to monitor response to treatment. Adjust therapy based on clinical and laboratory findings. Timely diagnosis and a tailored treatment plan are essential for the effective management of anaemia and for preventing complications.
Future Challenges
Despite global efforts, anaemia remains a significant public health challenge. Addressing the root causes—poverty, malnutrition, and inadequate healthcare—requires sustained, multifaceted strategies supported by global and local initiatives.
Disclaimer- The views and opinions expressed in this article are those of the author and do not necessarily reflect the official policy or position of M3 India.
About the author of this article: Dr Kranti Yadav, M.B.B.S. resident in MD Community Medicine ,Government Medical College, Nagpur
-
Exclusive Write-ups & Webinars by KOLs
-
Daily Quiz by specialty
-
Paid Market Research Surveys
-
Case discussions, News & Journals' summaries